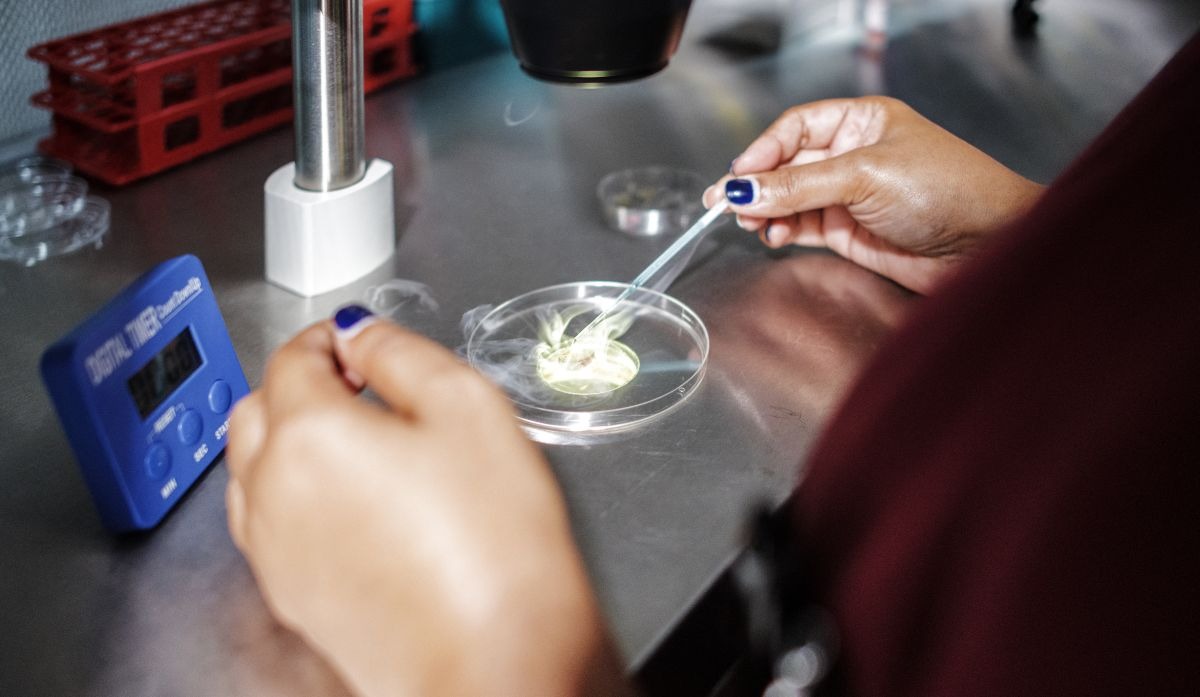

Un equipo de científicos dice haber ensamblado por fin el plano genético completo de la vida humana, al añadir las piezas que faltaban a un rompecabezas que casi fue completado hace dos décadas.
Mira esto: EE.UU. anuncia 35 mil visas de trabajo temporal por la falta de mano
En una investigación publicada el jueves en la revista Science, el grupo de investigadores internacionales describió la primera secuenciación del genoma humano completo, es decir, el conjunto de instrucciones para construir y mantener a un ser humano. Los trabajos previos, celebrados en todo el mundo, estaban incompletos debido a que las tecnologías de secuenciación de ADN de la época no eran capaces de leer ciertas regiones genómicas. Incluso después de las actualizaciones, faltaba aproximadamente el 8% del genoma.
“Algunos de los genes que nos hacen inequívocamente humanos estaban en realidad en esta ‘materia oscura del genoma’ y faltaban por completo”, dijo Evan Eichler, investigador de la Universidad de Washington que participó en este proyecto y en el Proyecto Genoma Humano original. “Se llevó más de 20 años, pero finalmente lo conseguimos”.
Muchas personas —incluidos los propios alumnos de Eichler— pensaban que el proyecto ya se había terminado. “Les estaba dando clases y dijeron: ‘Espera un momento. ¿No es esta como la sexta vez que ustedes han cantado victoria?’ Les dije: ‘No, ¡esta vez realmente lo logramos!’”.
Según los científicos, esta imagen completa del genoma le dará a la humanidad una mayor comprensión de nuestra evolución y biología, además de abrir la puerta a descubrimientos médicos en áreas como el envejecimiento, las afecciones neurodegenerativas, el cáncer y las enfermedades cardíacas.
“Estamos ampliando nuestras oportunidades para entender las enfermedades humanas”, dijo Karen Miga, autora de uno de los seis estudios publicados el jueves.
Con esta investigación concluyen décadas de trabajo. El primer borrador del genoma humano fue anunciado en una ceremonia celebrada en la Casa Blanca en el año 2000 por los responsables de dos entidades que competían entre sí: Un proyecto internacional financiado con fondos públicos y encabezado por una agencia de los Institutos Nacionales de Salud de Estados Unidos, y una empresa privada, Celera Genomics, con sede en Maryland.
El genoma humano está formado por unos 3.100 millones de subunidades de ADN, pares de bases químicas conocidas por las letras A, C, G y T. Los genes son cadenas de estos pares identificados con letras que contienen instrucciones para fabricar proteínas, los componentes básicos de la vida. Los seres humanos tienen unos 30.000 genes, organizados en 23 grupos llamados cromosomas que se encuentran en el núcleo de cada célula.
Fuente: AP
VIDEO RECOMENDADO
¿Qué dice la Ciencia sobre la masturbación?